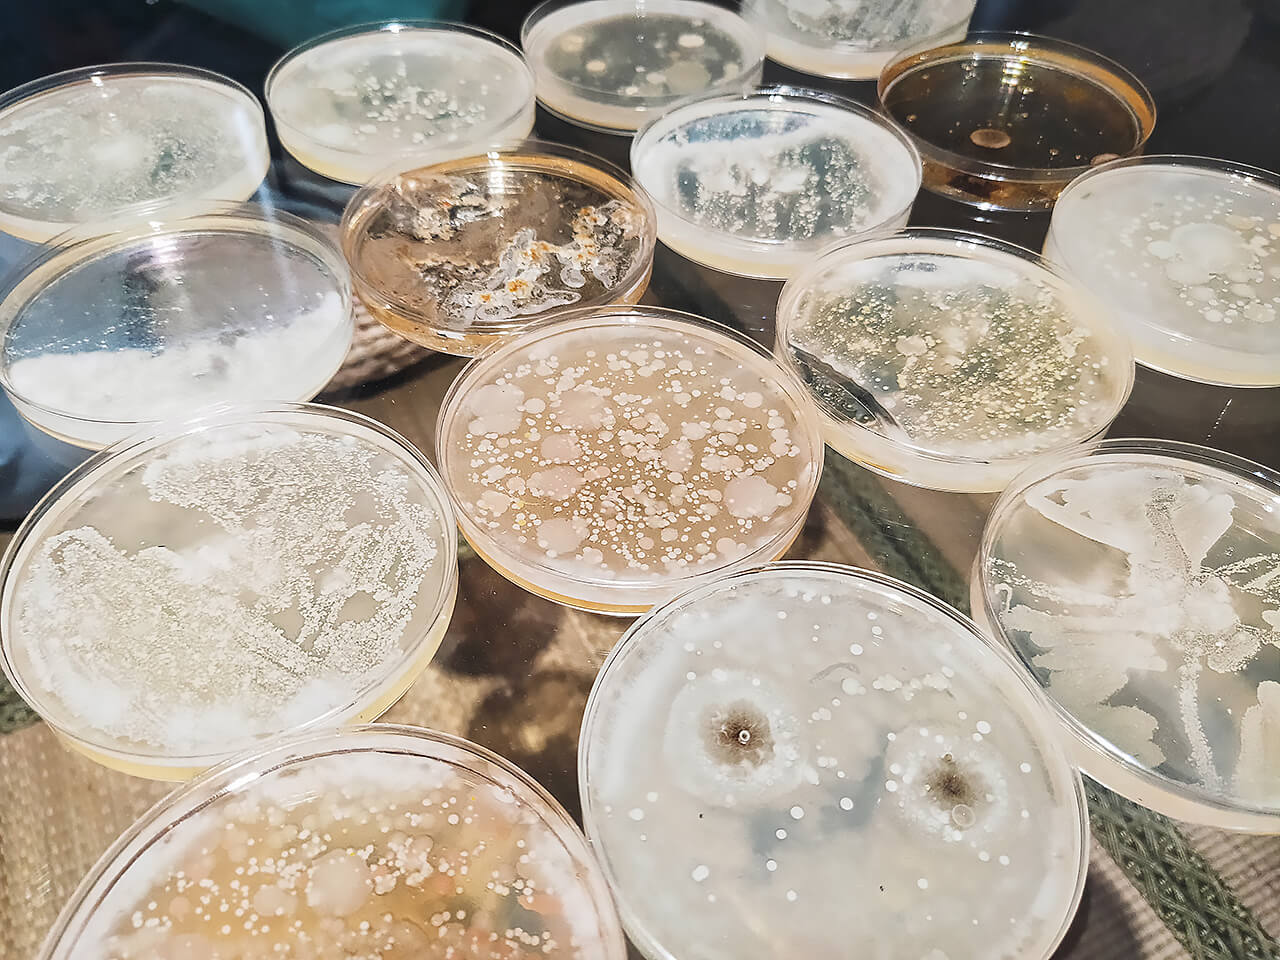

你曾經看過生物藝術嗎?
當生物藝術與科技結合又會是什麼模樣?
去年曾跟房客們聊到,分享了許多展覽以來,大家最容易感興趣的就是設計展,而最不容易了解的則是當代展;不過,這次要分享生物藝術的展覽,也會連結到過去曾介紹過設計展,有時候不同類型的展覽,也有可以相互思考、相互連結的共通之處!

到底是真的還是假的?藝術家所虛構的現實
在分享展覽之前,先問問大家在看展時,是否也曾忍不住思考「這是真的還是假的?」
3月在空總展開的展覽《虛幻生命:混種、轉殖與創生》,或許也是一場會讓你分不清真假的展覽!女子過去的觀展經驗,有時候都會看到「藝術家去虛構一種現實」,而這類型的作品,經常模糊了現實與虛構的界線,像是一場驚喜又像是一場惡作劇,讓你懷疑真實性,卻又會讓你忍不住會心一笑。

空總這場展覽,也有許多介於虛構及現實之間的作品,也會讓人忍不住思考作品的真實性,像是:
羊男真的存在嗎?
草木可以發電嗎?
病毒可以變成食譜?
胎盤可以製作成指南針?
在分不清真假的作品背後,都是藝術家想談論、表達的概念。看到這裡,你有沒有覺得這樣的概念很熟悉呢?之前分享過的推測設計展《準現實》也有著類似的概念,透過實體的設計物,倒過來回應社會之下某項議題或概念。

這種「虛構出一種現實」的呈現方式,女子認為最容易被大眾理解、也最貼近生活的例子就是「聖誕老人」!
小時候你也會相信聖誕老人嗎?即便沒看過聖誕老人(本尊),為什麼也會相信有聖誕老人存在呢?因為大人或父母都準備好「禮物」來佐證聖誕老人的存在;這樣就像是「一種虛構的現實」,即使還不了解概念是真是假,卻也有其他人事物可以幫忙呼應/佐證這些概念。
這類型的展覽也會讓人覺得很有意思,不管是藝術家或設計師,都會透過創作實體物件(羊男雕塑、3D列印的陽具等等)或錄像(虛構的表演、紀錄)等創作方式,來佐證或傳達某個概念,並虛構出一種概念之下的現實。
。延伸看展:動物基因混合而成的超級陽具?推測設計展《準現實》
多面向的生命,混種、轉殖與轉生
這場展覽是一場以生命、生物為主軸所展開的展覽,不過展覽所談論的生命並不僅限於現實,更多了一分虛構與空想的想像,不只有生物科技與藝術,也多了一些生命與道德拉扯的詮釋。


空想生物的生命《大衛》、《安妮》與《蘿莉塔》
這次觀展女子也較喜歡有想像意象的作品,像是黃贊倫的藝術雕塑裝置《大衛》、《安妮》及《蘿莉塔》,空想的生物多了一點詩意與感性的浪漫。
而羊男、羊女的藝術雕塑,其實也是可互動的裝置。被置於貨櫃箱中的羊男《大衛》每到特定時間,就會開始用頭部敲打前方的玻璃,規律且沈重的悶響聲,便會在展場中迴盪,像是一種消極又沉悶的反抗,也會讓人不禁思考,每一件被裝載於貨櫃箱中的生命,是不是也曾像這樣反抗過?


燒製胎盤所製作而成的指南針《血基質》
除了虛構生命的雕塑以外,也有一些真實製作的作品,像是作品《血基質》便是以69個人類胎盤血所製作而成的指南針,細小的指南針被放置在玻璃碗中轉動,一旁有燒製成指南針的紀錄錄像,牆面上也有著69個捐贈胎盤的重量與出生日期,胎盤被燒製過後,就成了另一種物件存在著。

去疾病化的腳下細菌《快樂腳》
生命轉化與轉變的作品,還有《快樂腳》及《病毒之愛》等,《快樂腳》是將大眾所排斥、會產生厭惡的腳下細菌,轉變為可以被觀看的花紋或圖樣,嘗試「去疾病化」,讓大家可以用更正向的態度來看待這些事物。

可食用的病毒的食譜《病毒之愛》
而《病毒之愛》則是曾在推測設計展《準現實》展出的作品,這次現場展出的作品更加完整,《病毒之愛》是透過設計病毒食譜、病毒餐以及食用病毒餐的錄像,來表現另一種新的觀看病毒的方式!
同樣的作品,觀察在不同策展脈絡下的語境也很有趣,上次是推測設計的展覽,而這次則是當代藝術的展覽,在不同的脈絡下,作品都提出了對未來的想像與可能。


後記
有些作品也探討生物與能源,草木發電、土壤的裝置,又或是討論「如果人類可以變小,是否就會有更多生存空間」的可能,其他的作品就留給大家去現場看看!如果你也喜歡當代展能帶給你更多的思考空間與想像,都可以來看看這場展覽,感受生命介於真實與虛構之間的擺盪,感受在藝術之下更多面性的生物樣貌。


《虛幻生命:混種、轉殖與轉生》
・展期|2021/03/13 – 2021/05/23
・時間|週二至週日 11:00 – 18:00(週一休館)
・地點|台灣當代文化實驗場 圖書館展演空間一、二樓
・票價|免票入場
展覽官網
|如果你也想了解更多展覽,歡迎來當我的房客|
📍追蹤更多展覽資訊:https://roomlife.cc/IG
📍發現展覽大小事:https://roomlife.cc/FB
看看其他的房間:







